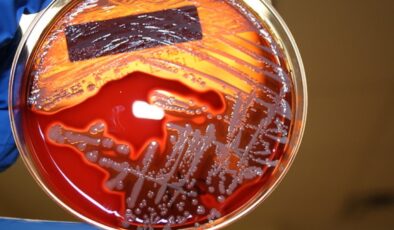

- Zonguldak Orman Bölge Müdürlüğü
- zeytin hastalıkları ilaçlama
- Yüzölçümünün yüzde 67'sinden fazlası zengin orman varlığıyla kaplı olan Kastamonu ve Batı Karadeniz genelinde
- yüzde çıkan sivilceye ne sürülür
- Yusuf Beyazıt Tokat haberleri
- yola odaklan kamu spotu
- Yeşilırmak taşkın riski.
- Yeşil Vatan koruma önlemleri.
- Yeşil Vatan koruma
- yeşil göz makyajı